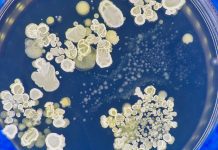

antibiotics Related News
Hidden gram-negative bacteria pose a serious threat to hospital patients
Carriers of gram-negative bacteria have a 14% chance of developing an antibiotic-resistant infection within 30 days of hospitalisation, according to a study from Amsterdam...
Perseverant bacteria are weakening antibiotic treatment
Bacterial perseverance is a new phenomenon that could help explain how bacteria are able to adapt to survive antibiotic treatment.
A team of researchers from...
Re-examining the safety of fluoroquinolones
A review into the use of fluoroquinolones has found discrepancies in the safety data issued by regulatory bodies.
Fluoroquinolones are commonly prescribed family of antibiotics....
New trial to assess rapid tests to reduce antibiotic prescribing
Funding has been allocated for a clinical trial assessing whether respiratory infection rapid tests could reduce antibiotic prescribing in primary care.
A research team from...
Dentists prescribed excessive antibiotics for toothache in pandemic
A new report from the University of Manchester highlights that dentists were forced to prescribe unnecessary antibiotics for toothache during the pandemic.
In the UK,...
Europe’s quest for new antibiotics
Rosa Castro of the European Public Health Alliance argues for an alternative to a transferable exclusivity extension to address the lack of new antibiotics.
At...
Metal-based antibiotics could be used as a fungal infection treatment
Researchers from the University of Bern have been developing new, metal-based drugs to treat fungal infections.
Over one billion people contract fungal infections each year....
Antibiotics in infancy may impact adult gut health
New findings show that antibiotics for preterm or low birth weight babies can lead to adverse adult gut health.
Preterm and low birth weight babies...
Extending the UK’s leadership with an antibiotic subscription model to tackle AMR
Following the UK’s top ranking in the recent AMR Preparedness Index, Michael Hodin and Peter Jackson discuss the country’s novel antibiotic subscription model and...
WHO: The development of new antibiotic treatments is stagnant
A WHO report highlights the lack of antibiotic treatment development and how this impacts the future of infection care.
In the annual pipeline report by...
Can antibiotics before a caesarean birth affect the baby?
Researchers explore whether antibiotics before a caesarean birth can increase the risk of early childhood conditions such as asthma.
Caesarean birth is common, with a...
Using antibiotics may cause inflammatory bowel disease
Research performed by a team at the NYU Grossman School of Medicine suggests that antibiotic use may cause older adults to develop inflammatory bowel...
Are antibiotics the answer to recurrent urinary tract infections?
New research suggests that antibiotics may increase recurrent urinary tract infections by disrupting the gut microbiome.
Urinary tract infections are caused by bacteria in the...
The importance of patient-centred care for resistance to antibiotics
HEQ spoke to Dr Neda Milevska-Kostova, chair of the International Alliance of Patients’ Organizations (IAPO) and chair a.i. of the AMR Patient Alliance about...
‘Antimicrobial resistance is a slow tsunami’
University of Oxford’s Professor Timothy Walsh reflects on the lack of immediacy and accountability in the fight against antimicrobial resistance (AMR) and why bolder...
NICE announces two new antimicrobial drugs coming to the NHS
Cefiderocol and ceftazidime-avibactam, two antimicrobial drugs, will be made available on the NHS with the hopes to tackle antimicrobial resistance.
The National Institute for Health...
Scientists develop synthetic antibiotics to tackle drug-resistant superbugs
Synthetic antibiotics could unlock the capability of killing drug-resistant superbugs and tackling the antimicrobial resistance (AMR) crisis.
A groundbreaking discovery by a team of scientists...
The effect of antibiotics after birth on gut microbes of babies
A new study has uncovered that treating babies with antibiotics in the first week of life affects their gut microbes, the ability to digest...
How can we alleviate the burden of antibiotic resistance?
Professor Colin Garner, CEO of charity Antibiotic Research UK, discusses how enhancing knowledge can help to mitigate antibiotic resistance.
Antibiotic resistance is a growing public...
Greater effort needed to reduce antimicrobial resistance, researchers say
Current measures to reduce antibiotic prescribing in primary care are not enough to prevent the rise of drug-resistant infection in England, a new report...